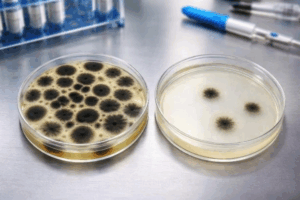

Problème de durée de vie et risque microbiologique après ouverture
Un client souhaitait commercialiser un produit alimentaire existant dans un format plus grand. Ce nouveau format impliquait une consommation prolongée après ouverture, ce qui augmentait le risque microbiologique au cours de l’utilisation.
L’enjeu était d’évaluer la robustesse du produit pendant toute sa période d’utilisation et de déterminer si la formulation originale permettait de maîtriser ce risque microbiologique ou si un ajustement était nécessaire.
Évaluation du risque microbiologique en conditions réelles d’utilisation
En l’absence de méthode normalisée, ACXEL SR a développé un protocole sur mesure basé sur des tests de provocation standards, intégrant plusieurs inoculations dans le temps afin de reproduire un usage réaliste du produit après ouverture.
Comparaison des formulations
- Comparaison de la formulation originale et d’un prototype ajusté
Analyse du danger microbiologique ciblé
- Essais réalisés sur Aspergillus niger, identifié comme principal microorganisme responsable du risque de détérioration
Simulation de l’utilisation prolongée
- Inoculation contrôlée du produit tous les 5 jours pendant 35 jours
- Suivi des comptes microbiologiques avant chaque nouvelle inoculation

Impact sur la conservation alimentaire et la durée de vie produit
L’évaluation du risque microbiologique a permis de générer des résultats concrets et directement exploitables :
- Mise en évidence que la formulation originale est performante à court terme, mais perd en efficacité après environ 20 jours
- Démonstration qu’un prototype ajusté maintient une meilleure stabilité microbiologique sur l’ensemble de la période
- Génération de données scientifiques objectives facilitant la prise de décision
- Définition d’une durée de vie « meilleur avant » de 20 jours basée sur des résultats mesurés
